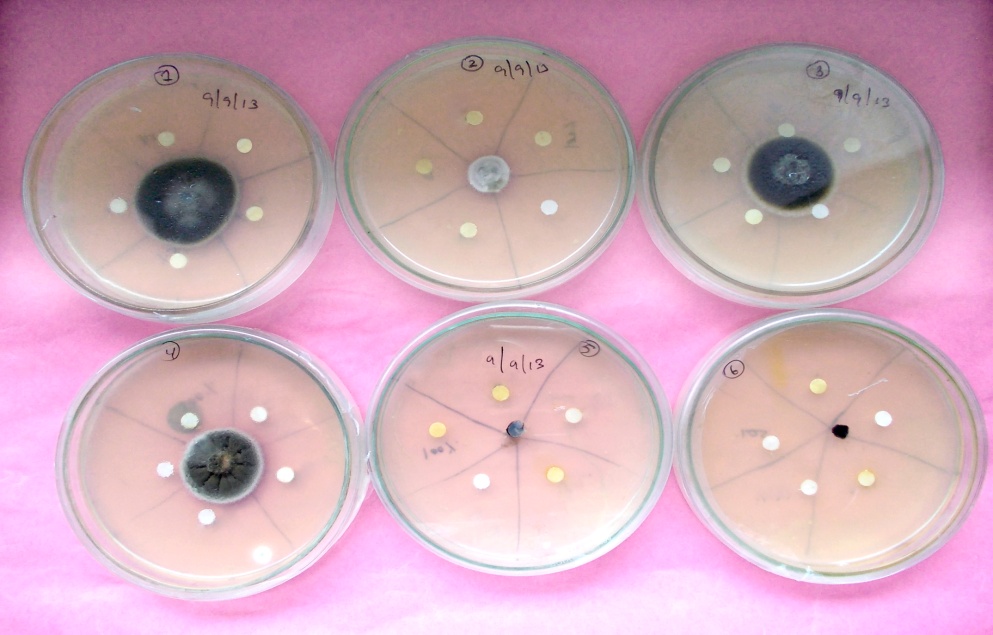

1S. R. F., Microbial Research Laboratory, Department of Botany, University College of Science, Mohanlal Sukhadia, University, Udaipur, 313001, Rajasthan, India, 2Prof. and Head Department of Botany, University College of Science, Mohanlal Sukhadia University, Udaipur, 313001, Rajasthan, India
Email: parveentahira06@gmail.com
Received: 21 Jan 2018, Revised and Accepted: 15 Apr 2018
ABSTRACT
Objective: In vitro antifungal activity of six essential oils of 1. Ocimum tenuiflorum (Purple leaves/Krishna Tulsi) 2. Cymbopogon citrates (Nimbu ghas), 3. Origanum majorina (Sweet majoram), 4. Ocimum citriodorum (Nimbu tulsi), 5. Ocimum bascillicum (Gulal tulsi), and 6. Ocimum sanctum (Green leaves/Shree tulsi) were investigated against economically important phytopathogenic fungi, Alternaria solani, isolated from infected chilly.
Methods: The experiment was carried out by Whatman paper disc method using Whatman paper No.3 on Potato Dextrose Agar with three replicates. Five concentrations of each essential oils i.e., 20, 40, 60, 80 and 100% were assayed against the test fungus. The experiment was carried out at 27ᵒC and mycelial growth was measured after every third day, up to 15 d using the statistical method.
Results: It is an evident from this study that all the oils used in this study are inhibiting test fungi, oil of O. bascillicum and O. sanctum are completely (100%) inhibiting test fungi.
Conclusion: It may be concluded from the above study that all the taken oils have a good potential to control plant pathogenic fungi and these could be considered for developing a new fungicide.
Keywords: Antifungal activity, Botanical oils, Chilly, Alternaria solani, Whatman paper disc method
© 2018 The Authors. Published by Innovare Academic Sciences Pvt Ltd. This is an open access article under the CC BY license (http://creativecommons.org/licenses/by/4.0/)
DOI: http://dx.doi.org/10.22159/ijcpr.2018v10i4.27660
Chilly (Capsicum annum L.) is an important tropical and subtropical crop on the basis of high consumption, nutritional and cash values to the farmers and consumers, both in developing and developed countries [1]. It is also an important cash crop of India. The world area and production of chilly is approximately 1.5 million hectares and 7 million tonnes, respectively. India accounts for 1.2 million tonnes of production annually, and is the largest producer in terms of international trade, exporting 20 per cent of its total production as dry chilly, chilly powder and oleoresins to over 90 countries [2]. India is also the largest consumer of chilly.
Chilies are rich in vitamins A, B, C, D and E besides minerals like molybdenum, manganese, foliate, potassium, thiamine and copper, it also contains proteins. Chilly contains seven times more vitamin C than an orange. Chilies are important medicinally and used as a tonic to ward off many diseases, it is good in slimming down, stimulates the appetite and digestive system and also helps to clear the lungs. It is also used in beverages [3].
Chilly belongs to the genus capsicum, under the family Solanaceae. It is vulnerable to many diseases and pests due to its extreme delicacy and succulence. Diseases caused by fungi and bacteria are major constraints to chilly production. In India, the first report of Alternaria sp. associated with chilly disease was made from Delhi by Dutt in 1937 [4]. Mathur and Agnihotri [5] reported fruit rot of chilly caused by Alternaria sp. from Rajasthan.
The Deuteromycetes fungal genus Alternaria is well known for its notoriously, virulent and destructive plant pathogenic members. The necrotrophic nature of Alternaria species typically leads extensive damage to the plant and harvest products. A great number of species were recorded for the genus Alternaria infecting different crops causing worldwide economic loss [6].
Alternaria solani is hosted by different species of the family Cucurbitaceae, Brassicaceae, Solanaceae which are having nutritional as well as economical food value [7-10]. It is ubiquitous in nature and causes early blight of potato and tomato, as well as potato tuber rot and tomato fruit rot etc. besides diseases in chilly [7-10].
A. solani overwinters in the form of mycelium and conidia in plant debris [10]. During vegetation, it spreads by conidia transported by wind and insects. The conidia quickly germinate and infect plants. The optimal temperature for their germination ranges from 28 ° to 30 °C.
For controlling the diseases, numbers of synthetic chemicals are used but indiscriminate use of fungicides may lead to toxic residues, development of fungicide resistance environmental pollution and carcinogenic chilly products [11]. Several effective pesticides have been recommended for use against this pathogen, but they are not considered to be long-term solutions, due to concerns of expense, exposure risks, fungicide residues and other health and environmental hazards [12]. In an attempt to modify this condition, some alternative methods of controls have been adopted. Natural products isolated from plants appear to be one of the alternatives as they are known to have minimal environmental impact and danger to consumers in contrast to synthetic pesticides [13].
In this context, a search for naturally occurring substances with potential biological activity continues in an increasing scale. Plant products are gaining importance in crop protection in view of their selective properties, low cast and safer alternative means to the ecosystem.
Hence botanical oils extracted from plants (which are concentrated liquid with volatile aromatic compounds, hydrophobic in nature) [14] seems to be an effective alternative to synthetic/chemical fungicides against phytopathogenic fungi, which is because of presence of biological active sesquiterpenes, monoterpenes including phenols, carbohydrates, ethers, alkaloids, quinons, flavonoids, aldehydes, ketones, alcohols, sterols, tannins and saponins etc. [15, 16]. Botanical oils are not phytotoxic as well as they are also a significant inhibitor of several fungal pathogens [17, 18].
Besides this many researchers have also reported the significant antifungal activity of essential oils, hence they could be used as effective antifungal agents [19-21]. In the present study, the selected essential oils were assayed against Alternaria solani for their antifungal activity.
Plant material
Aerial parts of selected plants were collected from growing fields from their natural habitats Udaipur, Rajasthan. The plant materials were dried under the shade condition with proper ventilation. Then were subjected to hydrodistillation to extract their essential oils.
Extraction of essential oil
Extraction of essential oil from subjected plants was carried out using Clevenger-type apparatus established by Montes et al., [22]. Air-dried plant material and distilled water were used then extraction was done for 4 h. anhydrous sodium sulfate was used to remove water after extraction. The resulting oil placed into sealed plastic tubes and was stored in a refrigerator at 4 °C [23]. Oils were diluted by acetone to make different concentrations just before they were used for the antifungal assay.
Isolation and identification of Alternaria solani
A. solani were isolated from asymptomatic chilly. Fragments of infected tissues were placed on potato dextrose agar (PDA) medium and incubated at 25 °C. It was placed for seven days to allow mycelial growth. The fragments excised from the mycelia developed were transferred onto fresh PDA medium then purified by monospore isolation. A. solani identified on the basis of colony morphology and microscopic observation of conidia. The obtained isolates were stored on PDA medium at 4 °C.
Identification of test plant
Test plants were washed blotted dry and the herbarium of three plants was sent to the Botanical Survey of India (BSI), Jodhpur, Rajasthan, for identification. Plant herbarium no.1 was identified as Ocimum tenuiflorum,[Voucher no. B. S. J. O.–2533], Plant herbarium no. 5 as Ocimum bascillicum [Voucher no. B. S. J. O.–22492], and Plant herbarium no. 6 as Ocimum sanctum [Voucher no. B. S. J. O. 5733].
In vitro antifungal activity test
The experiment was carried out by Whatman paper disc method using Whatman paper No.3. Discs of 6 mm impregnated with 10 μl (of various concentrations from 20% to 100%) of different essential oils were placed separately around the 6 mm disc of test fungi (which is placed inverted at centre in the PDA plate). The Petri plates were incubated at 28±1 °C. Mycelial growth was measured in each Petri plate after every third day, up to 15 d. The controls were used for each case by not exposing the fungus to any oil respectively. Qualitative and quantitative analysis of fungicidal activity was done by following the Deans and Svoboda 1990 [24].
Inhibition (%) = [(C-T)/C] x 100
Where: C is the diameter of the fungal colony in control plate (mm) and T is the fungal colony diameter in treatment plate (mm).
Statistical analysis
Experiments were performed in triplicates and data were analyzed by taking their mean.
The result of antifungal activity assay of selected essential oils of O. tenuiflorum, C. citrates, O. majorina, O. citriodorum, O. bascillicum and O. sanctum had an inhibitory effect on the fungal mycelial growth. All the six essential oils at all the taken concentrations inhibited the growth of test fungi up to various levels. Among all the six oils used against the test fungus, O. basilicum and O. sanctum inhibited the test fungus completely (100%) at all the taken concentrations.
All the taken species are reported to have significant antifungal activity [24-26].
Result images and details of pathogen mycelium inhibition are shown below in the fig. 1 and table 1 respectively.
Table 1: Mycelial growth inhibition (%) of Alternaria solani on 3rd, 6th 9th 12th and 15th Day
| Day | O. tenuiflorum | C. citrates | O. majorina | O. citriodorum | O. bascillicum | O. sanctum | Control |
| 3rd Day | 100% | 100% | 100% | 100% | 100% | 100% | NI |
| 6th Day | 90% | 100% | 100% | 100% | 100% | 100% | NI |
| 9th Day | 84% | 100% | 90% | 84% | 100% | 100% | NI |
| 12th Day | 70% | 90% | 70% | 78% | 100% | 100% | NI |
| 15th Day | 55% | 78% | 58% | 64% | 100% | 100% | NI |
Note: NI= No Inhibition
Fig. 1: Radial growth of Alternaria solani after 15 d of inoculation with different doses of essential oils: 1. Oscimum tenuiflorum, 2. Cymbopogon citrates, 3. Origanum majorina 4. Ocimum citriodorum 5. Oscimum bascillicum, 6. Ocimum sanctum
Note: Inhibition in the mycelial growth of Alternaria solani was found to be independent from concentrations i.e. from 20%, 40%, 60%, 80% and upto 100%
According to the present investigation, it can be concluded that the essential oils of all the selected plants exhibited significant antifungal activity against the economically important plant pathogenic fungus A. solani. Hence it can be concluded that these selected oils could lead to the development of a new environmental friendly antifungal agent, which may be used as a major constituent in the biopesticides against many plants diseases caused by the test fungus after the proper clinical trials.
We would like to sincerely thank Dr. Vinod Maina (Head, BSI Jodhpur), Dr. Kusum Mathur (Retd. Head Dept. of Plant Pathology, RCA Udaipur), Dr. Anila Doshi (Head, Dept. of Plant Pathology, RCA Udaipur) for their cooperation in identification of plants and isolation and identification of pathogen respectively for the research. Financial assistance received from the UGC, Government of India is also gratefully acknowledged.
All the author have contributed equally
Declared none
REFERENCES
Sundaramoorthy S Usharani, AP George. Antifungal activity of plant products for the management of fruit rot infection in Chillies. Plant Pathol J 2014;2:87-99.
Singhal V. Indian agriculture. Indian Economic Date Research Centre, New Delhi, India; 1999. p. 197-8.
Thamaraikannan M, G Palaniappan, C Sengottuvel. Market survey 30 facts for you, by: time to step up chilli exports facts for you; 2011.
Dutt KM. Alternaria species of chilli in India. Curr Sci 1937;6:96-7.
Mathur RL, Agnihotri JP. Internal mould of chillies caused by Alternaria tenuis Auct. Indian Phytopath 1961;14:104-5.
Kirk PM, Cannon PF, Minter DW, Stalpers JA. Dictionary of the Fungi. 10th ed. Wallingford, CABI; 2008. p. 22.
Agrios GN. Plant pathology. 3rd edition. Academic Press: INC. San Diego, New York, Berkeley, Boston, London, Sydney, Tokyo, Toronto; 1988.
Brooks FT. Plant diseases. Geoffrey Cumberlege. Oxford University Press: London, new York, Toronto; 1953.
Holliday P. A dictionary of plant pathology. Cambridge University Press: Cambridge, New York, New Rochelle, Melbourne, Sydney; 1989.
Kochman J. Fitopatologia. PWRiL. Warszawa; 1973.
Rajavel R. Seed borne Colletotrichum capsici (Syd). Butter and Bisby and its management. M. Sc. Thesis, Tamil Nadu Agricultural University, Coimbatore, India; 2000.
Yanar Y, Ayhan G, Izzet Kadioglu, Halit C, Mark W. In vitro antifungal evaluation of various plant extracts against early blight disease (Alternaria solani) of potato, Afr J Biotechnol 2011;42:8291-5.
Varma J, Dubey NK. Prospectives of botanical and microbial products as pesticides of Tomorrow. Curr Sci 1999;76:172-9.
Soylu EM, Soylu S, Kurt S. Antimicrobial activities of the essential oils of various plants against tomato late blight against Phytophthora infestans. Mycopathologia 2006;161:119-28.
Burt S. Essential oils: their antibacterial properties and potential applications in foodsa review. Int J Food Microbiol 2004;94:223–53.
Kalemba D, Kunicka A. Antibacterial and antifungal properties of essential oils. Curr Med Chem 2003;10:213–29.
Chuang PH, Lee CW, Chou JY, Murugan M, Shieh BJ, Chen HM. Antifungal activity of crude extracts and essential oil of Moringa oleifera Lam. Biores Tech 2007;98:232-6.
Pandey DK, Tripathi NN, Tripathi RD, Dixit SN. Fungitoxic and phytotoxic properties of the essential oil Caesulia axillaris Roxb. Angew Bot 1982;56:259–67.
Adam K, Sivropoulu A, Kokkini S, Lanaras T, Arsenakis M. Antifungal activities of Origanum vulgare subsp. hirtum, Mentha spicata, Lavandula angustifolia and Salvia fruticosa essential oils against human pathogenic fungi. J Agric Food Chem 1998;46:1739–45.
Bowers MN JH, Locke JC. Effect of botanical extracts on the population density of Fusarium oxysporum in soil and control of Fusarium wilt in the greenhouse. Plant Dis 2000;84:3-6.
Sokmen A, Jones BM, Erturk M. The in vitro antibacterial activity of Turkish medicinal plants. J Ethnopharmacol 1999;67:79-86.
Montes MO, Munoz L, Wilkomirsky YT. Plants medicinales de uso en Chile. Quimicay farmacologia. Editorial Universitaria, Santagiago, Chile; 2001. p. 330.
Negahban M, Moharramipour S, Sefidkon F. Insecticidal activity and chemical composition of Artemisia sieberi Besser essential oil from karaj Iran. J Asia Pac Entomol 2006;9:61–6.
Deans SG, Svoboda KP. The anifungal properties of margoram (Origanum majorana L.) volatile oil. Flavour Fragrance J 1990;5:187-90.
Gomathinayagam Subramanian, Brij B Tewari, Rekha Gomathinayagam. Studies of antimicrobial properties of different leaf extract of tulsi (Ocimum tenuiflorum) against human pathogens. Am Int J Contemporary Res 2014;4:149-57.
Sethi S, Om Prakash, M Chandra, H Punetha, AK Pant. Antifungal activity of essential oils of some Ocimum species collected from different locations of Uttarakhand. Indian J Natl Prod Res 2013;4:392-7.